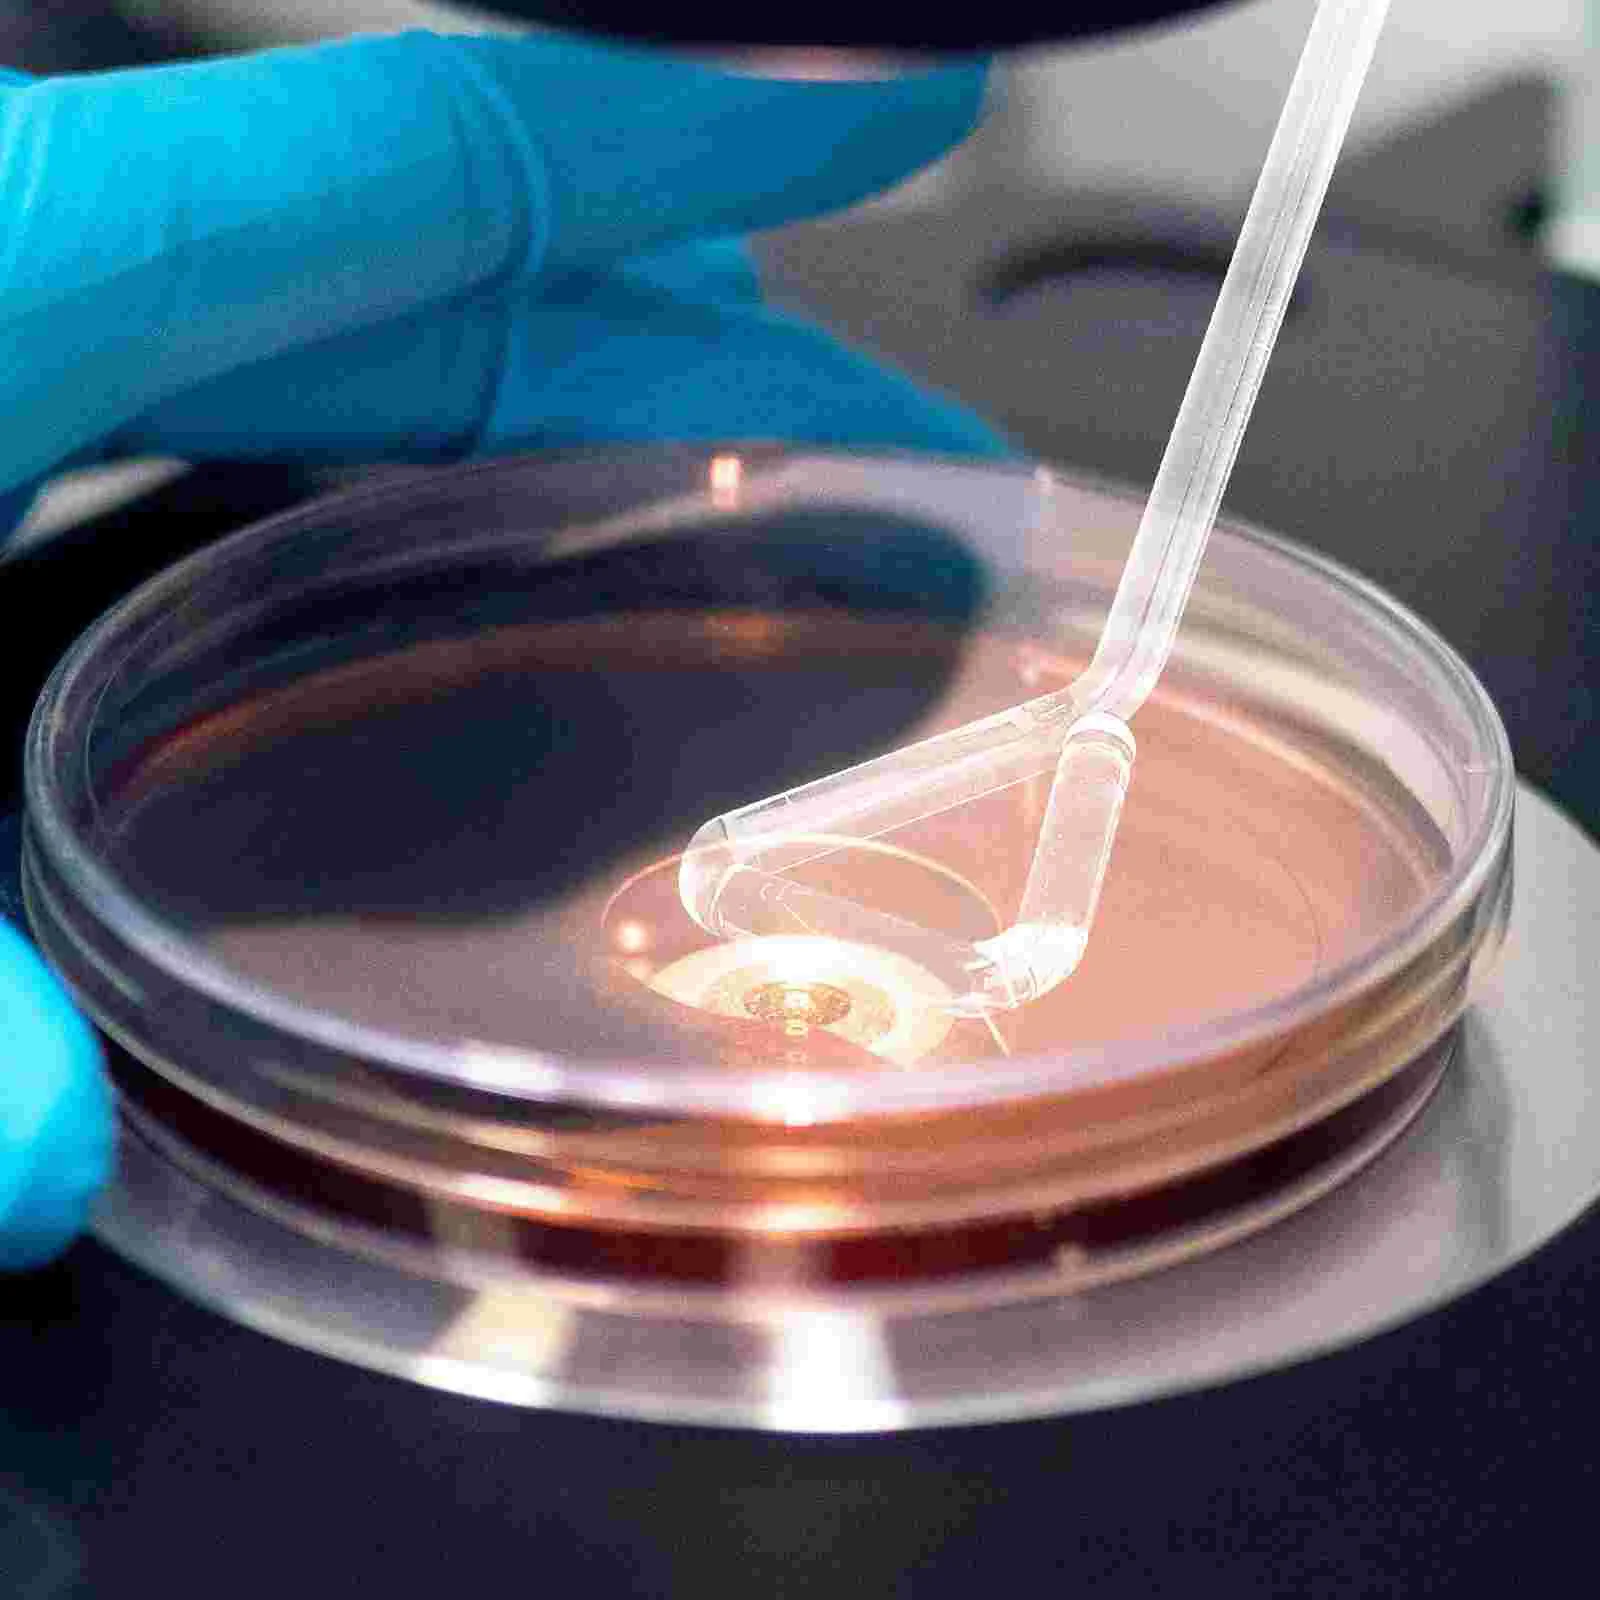
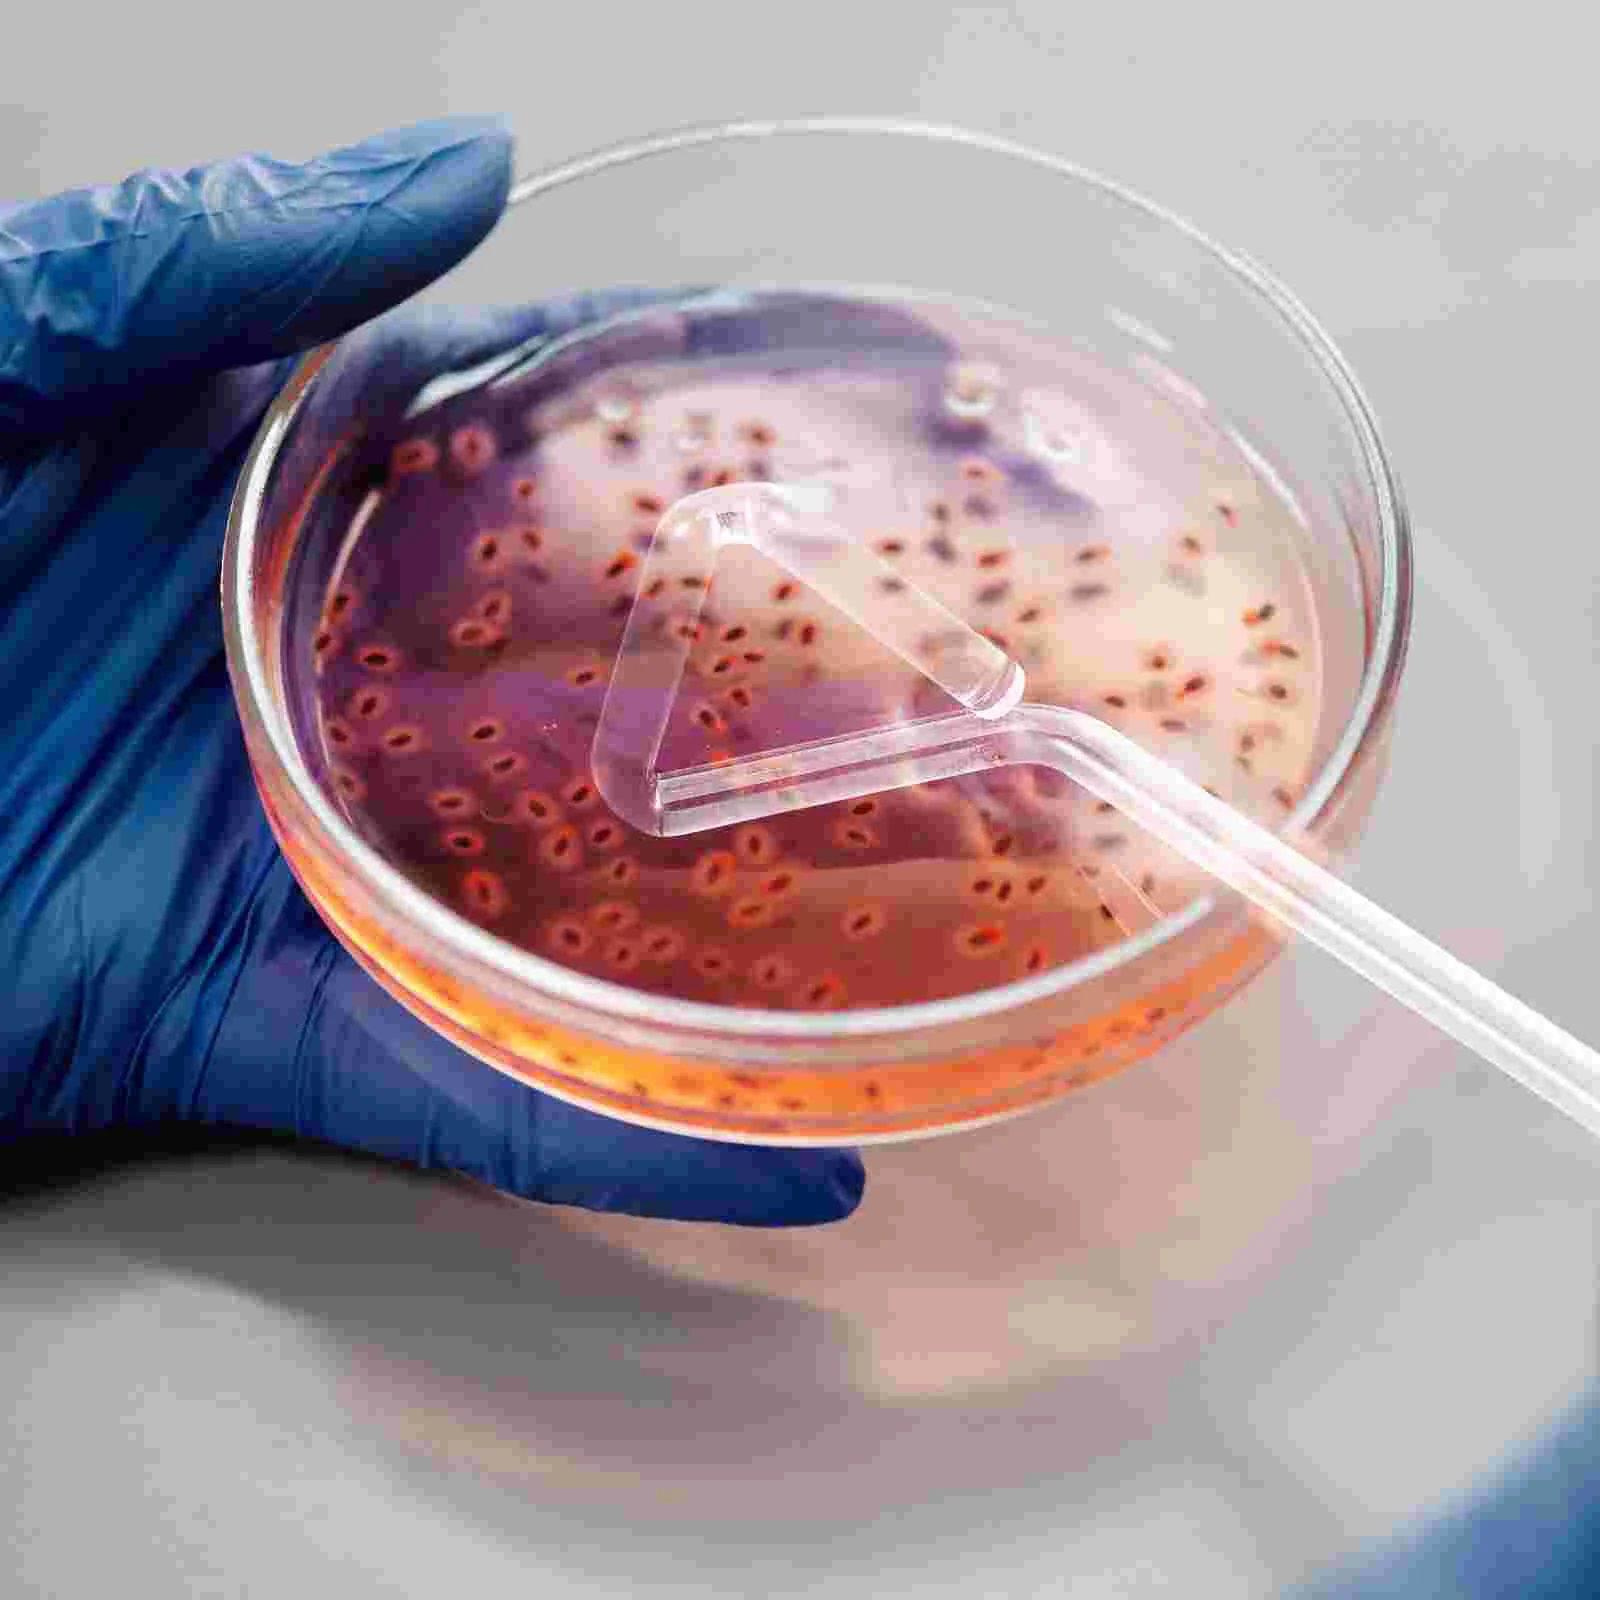

4 Pcs Coating Rod Spreader Culture Scientific Cell Science Experiment Tool Applicator
Price history chart & currency exchange rate
Customers also viewed

$20.67
Kit DIY For BT101IW01 V.0 BT101IW03 V.0 1024x600 40Pin LVDS Analog TV Laptop Panel 10.1" HDMI+VGA+AV+USB Driver Controller Board
aliexpress.com
$6.01
Pikachu Baby Small School Bag Boys and Girls Cute Plush Baby Children's Backpack Going Out Small Backpack
aliexpress.com
$5.78
Китай, Гуанчжоу, туристический сувенир, украшение, паста, холодильник, фотопаста, башня Гуанчжоу, тур, жемчужная река, коллекция
aliexpress.com
$1.94
45Pcs Cute Cat Stickers Vinyl Decals Animals Kitten Sticker For Bottles Laptop Computer Phone DIY Diary Scrapbooking Decoration
aliexpress.com
$56.66
Ganeed Industrial Vintage Pendant Light Rustic Hanging Lamp Metal Shades Adjustable Rope Light for Dining Living Room Home
aliexpress.com
$99.89
LDSKI Ski Pants Winter Women Men Zipper Design Trouser Waterproof Windproof Snow Skirt Reflective Snowboarding Outdoor Sports
aliexpress.com
$71.92
Mirror Cover For BMW X3 G01 X4 G02 X5 G05 Upgrade M Style xDrive28i xDrive35i xDrive40i Side Rear View Mirror Cover 2018 2019
aliexpress.com
$10.08
JIANKYD 1Pair Compression Socks for Women & Men Circulation, 20-30 mmHg is Best Support for Athletic Running Hiking
aliexpress.com
$4.63
Easy To Install Module Step Down Power Output Adapter Dual Usb Car Power Converter Wide Application Durable Practical 80mv 15w
aliexpress.com
$4.01
360 Rotatable Car Phone Mount Mobile Phone Bracket Navigation GPS Stand Phone Holder Car Accessories
aliexpress.com
$4.59
Kitchen Cloth Window Covers Home Hanging Door Curtain Partition Mesh Portable Doorway Curtains Closet Bedroom
aliexpress.com
$419.66
Комплект для ванной, 4 предмета Bau (Тумба 80, графит + раковина D41 + смеситель + выпуск), Бежевый
goods.ru
$14.28
2023 Læder Planlægger A5 5.8×8.3 tommer Kontor / Bedrift Læder SoftCover Bærbar Klassisk Med Pen Loop Planlægger 200/416 sider til Skole Kontor Traveller
lightinthebox.com
$34.35
Juego de manteles individuales navideños con patrón de cuadros rojos, mantel de cocina de Papá Noel con copos de nieve, tapete de mesa de lino decorativo
miniinthebox.com
$12.23
20-25cm Head Natural Preserved Anna Hydrangea With Stem Eternal Display Flower Bunch For Wedding Home Decoration DIY Bouquet
aliexpress.com
$3.47
decorative flowers & wreaths 10pcs artificial pu rice fruit home wedding succulent plants flower party decoration simulated hydrangea
dhgate.com
$27.74
Watch Bands Band For DATEJUST DAY-DATE OYSTERPERTUAL DATE Stainless Steel Strap Accessories 13 17 20 21mm Bracelet
dhgate.com
$26.77
JMT гармоничный двухцветный вязаный тяжелый вязаный модный дизайнерский свитер для собак
aliexpress.ru
$27.48
Car Styling For Hyundai Santa Fe ix45 2013 2014 2015 Stainless Steel Side Exterior Center Window Trims B+C Pillar 6Pcs
aliexpress.ru
$74.32
my888 cross-border plus size women's clothing 2021 autumn/winter new suit trumpet sleeve fashion suit amazon new arrival
fordeal.com
$15.33
For Samsung Galaxy Note20 Ultra Case Cover Note 20 U Shockproof Bumper Smooth Armor Phone Case
aliexpress.com
$10.30
Flexible Floating Swimming Pool Automatic Chlorine Dispenser Blue and White Tablet Dosing Device Outdoor Tubs Accessories
aliexpress.ru
$4.78
Влагонепроницаемый бытовой полупрозрачный герметичный контейнер для хранения с крышкой, пластиковый прозрачный контейнер для фруктов
aliexpress.ru
$5.89
J0919379A вне окружающего воздуха Температура температура Сенсор для VW Audi сиденье Skoda OCTAVIA III
aliexpress.ru
$944.57
chandeliers ring design modern led chandelier el lobby light ac110v 220v long dinning room fixtures
dhgate.com
$14.89
105 Color Eyeshadow Palette Highly Pigmented Matte Glitter Neon Eyeshadow Palette Makeup With Blush Powder All In One Gift Set
aliexpress.com
$23.33
Camera Cage With Handle Grip for Canon SONY Panasonic Slr Cameras Stabilizer Film Movie Making Kit Photography Bracket Parts
aliexpress.com
$11.05
Baitcasting Reel Aluminium Alloy Fishing Reel Magnetic Brake 13+1 Stainless Steel BB Casting Tackle Fishing Goods
aliexpress.com
$2.75
masks men women kids filter pm2.5 air pollution mouth face mask winter anti dust carbon insert designer printed washed reusable masks #73#46, Black
dhgate.com